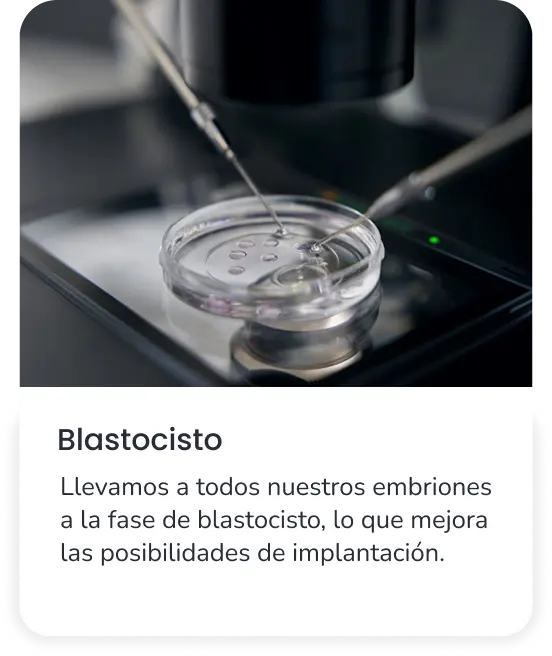
Blastocisto

Pide tu consulta de fertilidad gratuita
Si buscas apoyo para lograr ese embarazo tan deseado,
en IGIN somos especialistas en medicina reproductiva a distancia.
Agenda tu consulta online gratuita con un médico experto en reproducción.
- Con Compromiso
- Vamos a conseguir tu embarazo.
- Queremos ayudarte
- A tu lado, estés donde estés
¿Por qué IGIN?

Atención 100% online

Velocidad
Tenemos el equipo, el conocimiento, la experiencia y los medios para encontrar una solución personalizada.

Tasa de éxito

Idiomas

Tecnología
Utilizamos técnicas innovadoras para lograr tu embarazo, con precios cerrados y sin sorpresas durante el proceso.

Proceso personalizado
Cada historia es distinta. Adaptamos el tratamiento a tus necesidades para que te sientas acompañada y segura desde el primer paso.
Nuestra tasa de éxito está por encima de la media nacional
Te acompañamos paso a paso, estés donde estés
Puedes contactarnos por email, teléfono o través del formulario online.
Concertaremos una primera consulta online, totalmente gratuita y sin compromiso, cuando mejor te venga.
En la primera consulta te conoceremos, recogeremos tus datos e historial clínico y finalmente te mandaremos un informe en el que te indicaremos aquellas pruebas o analíticas que debas realizarte.
Este documento también lo recibirá tu ginecólogo, y podrás realizar las pruebas con él.
Cuando tengas los resultados, podrás enviárnoslos por email. Tras recibirlos, nuestros profesionales los estudiarán para diseñarte un tratamiento individualizado.
Te contactaremos para cerrar una segunda consulta online.
En esta cita te explicaremos los resultados obtenidos en las pruebas, nuestra valoración y el tratamiento a realizar.
Te indicaremos la pauta médica, explicándote todo el procedimiento y resolviendo dudas.
Te enviaremos por mail toda la información del ciclo y las recetas de la medicación. Este informe se le enviará también a tu ginecólogo.
Con la regla que tú quieras empezarás tu ciclo de medicación y realizarás con tu ginecólogo los controles ecográficos que indiquemos.
Estos (y analíticas si fueran necesarias) serán en días laborables y nos mandarás por email los resultados antes de las 19h. para estudiarlos.
Esta rutina se mantendrá hasta que consideremos que ha llegado el momento de la punción para extraer tus óvulos (en el caso de una FIV/ICSI). Entonces te daremos cita para acudir a nuestra clínica de Bilbao.
En el caso de haber una extracción de óvulos propios (FIV/ICSI) vendrás a nuestro centro. El procedimiento dura apenas quince minutos.
Podrás volver a tu lugar de residencia esa misma mañana. Tu pareja, si la tuvieras, dejará una muestra seminal.
La fecundación mediante microinyección intracitoplasmática (ICSI) y el desarrollo embrionario monitorizado por Embryoscope+ tienen lugar en nuestro laboratorio de Bilbao, al cargo de los mejores profesionales del sector y equipado con la tecnología más avanzada.
Cuando tus embriones lleguen al estadio de blastocisto (tras cinco o seis días) y estén listos para su implantación endometrial, te contactaremos para darte cita de nuevo en nuestras instalaciones de Bilbao para la realización de la transferencia embrionaria.
Te desplazarás por segunda y última vez a nuestra clínica en Bilbao para que te implantemos el embrión mediante transferencia.
Puedes regresar a tu ciudad esa misma mañana y retomar tu vida con normalidad.
Entras entonces en la conocida como «betaespera»: los diez o doce días que transcurren antes de realizarte la prueba de embarazo BHCG (analítica para la detección de embarazo) en un laboratorio de tu zona que te indicaremos.
El resultado positivo se confirmará con una ecografía que te hará tu ginecólogo.
Tratamientos personalizados
Adaptamos una amplia variedad de tratamientos a tus necesidades e historial médico
Realizamos exhaustivos estudios de compatibilidad genética y técnicas de transferencia específicas que nos permiten optimizar la eficacia de todos nuestros procedimientos.
Todos los tratamientos incluyen las ecografías y analíticas que necesites.
Toda nuestra tecnología, incluida desde el primer día
Sabemos lo importante que es sentirte tranquila desde el principio.
Por eso, en IGIN tendrás un precio cerrado desde la primera visita, con todas las tecnologías incluidas y sin costes adicionales.

Nos mueven historias de éxito como estas
Ut enim ad minim veniam, quis nostrud exercitation ullamco laboris nisi ut aliquip ex ea commodo consequat.

Paciente de FIV
Ut enim ad minim veniam, quis nostrud exercitation ullamco laboris nisi ut aliquip ex ea commodo consequat.

Paciente de ovodonación
Ut enim ad minim veniam, quis nostrud exercitation ullamco laboris nisi ut aliquip ex ea commodo consequat.

Paciente de DGP
Preguntas frecuentes
Lorem ipsum dolor sit amet, consectetur adipiscing elit. Ut elit tellus, luctus nec ullamcorper mattis, pulvinar dapibus leo.
Lorem ipsum dolor sit amet, consectetur adipiscing elit. Ut elit tellus, luctus nec ullamcorper mattis, pulvinar dapibus leo.
Lorem ipsum dolor sit amet, consectetur adipiscing elit. Ut elit tellus, luctus nec ullamcorper mattis, pulvinar dapibus leo.



